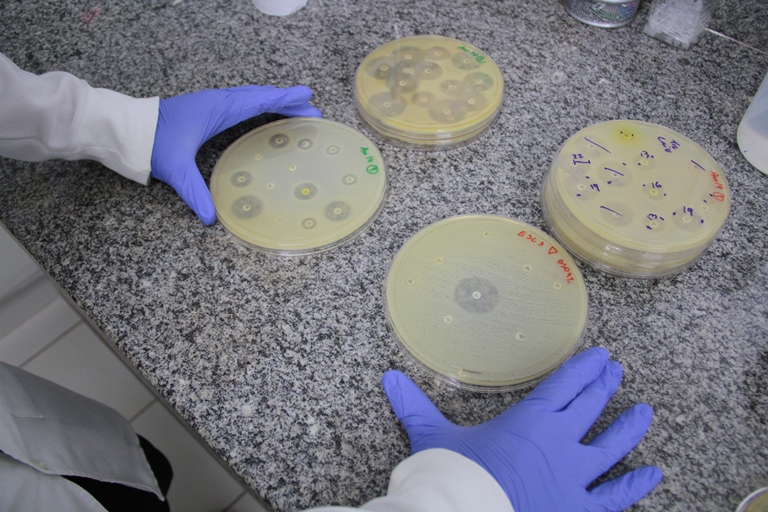

Alunos do curso de Medicina da Unaerp levam alegria para idosos da Casa do Vovô
Alunos do curso de Medicina da Unaerp levam alegria para idosos da Casa do VovôAção conhecida como trote solidário levou os calouros do curso de Medicina da Unaerp visitaram a Casa do Vovô
Prazo final é dia 03 de fevereiro. Inscreva-se!
Nando Araújo discutiu o tema nas universidades Fernando Pessoa e do Porto
A alumni Fabiana Pim encontrou na Unaerp a base para construir uma carreira sólida
Estudo sobre superbactérias é destaque em Retrospectiva 2019 da FAPESP
Estudo sobre superbactérias é destaque em Retrospectiva 2019 da FAPESPMatéria mencionada refere-se à pesquisa desenvolvida pelo professor André Pitondo da Silva, divulgada na revista internacional Journal of Global Antimicrobial Resistanc
 Relações Internacionais da Unaerp conquista 6º lugar em concurso promovido pelo Ministério da Defesa
Relações Internacionais da Unaerp conquista 6º lugar em concurso promovido pelo Ministério da DefesaEgressos do curso foram premiados pelo IV Concurso de Monografias sobre Defesa Nacional. Entrega do prêmio aconteceu dia 11 de dezembro, em Brasília
 Vídeo sobre hip hop leva primeiro lugar em concurso nacional
Vídeo sobre hip hop leva primeiro lugar em concurso nacionalMaterial foi produzido pelo aluno de Jornalismo, Felipe Ungaretti, com apoio da TV Unaerp
 Rose Hoeppner participa do 2º Desafio 100 X 100 Nada Melhor
Rose Hoeppner participa do 2º Desafio 100 X 100 Nada MelhorAtleta da Unaerp foi a segunda mulher a completar prova; competição contou com a participação de 50 pessoas
“Alimente o próximo neste natal” foi o tema da ação que beneficiou duas instituições da cidade
















